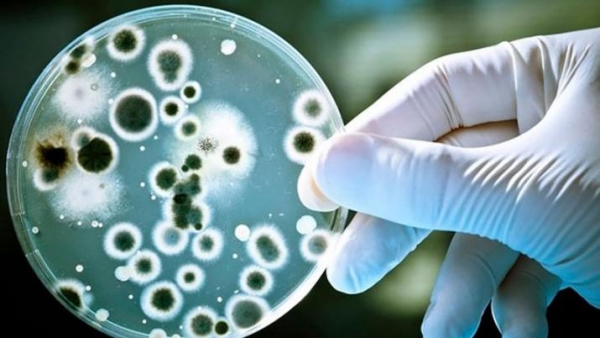

Estreptococo: ya hay 10 muertos por el ataque de la bacteria letal
hace 7 años - NACIONALES
Tiempo de lectura: 2 minutos, 25 segundosLas nuevas víctimas mortales del steptococccus pyogenes son un adolescente de la ciudad rionegrina de Cipolletti y un adulto de Mar del Plata.
La bacteria steptococcus pyogenes se cobró nuevas víctimas fatales en distintos puntos del país, entre ellas un chico de 2 años de la localidad bonaerense de Olivos, otro de Catamarca, un adolescente de Cipolletti y un anciano de Mar del Plata, por lo que ya son diez las muertes vinculadas al mismo germen.
Uno de los casos es el de un niño de 2 años que iba a la guardería de un colegio del partido bonaerense de Vicente López y murió el último domingo en Miami, a donde había viajado con su familia de vacaciones.
"Si bien no lo tenemos confirmado con análisis de Estados Unidos, los síntomas que tuvo el nene de 2 años coinciden con los de la bacteria", indicó a NA un vocero del Ministerio de Salud bonaerense.
Y agregó: "El nene se fue de viaje con la familia y cuando salió del país tenía una angina común. No sabemos si empeoró o si la bacteria colonizó algún órgano porque nos faltan los estudios epideomológicos finales".
Con respecto al caso de un hombre de 77 años que falleció en las últimas horas en la ciudad de Mar del Plata, el vocero de la cartera de Salud consultado explicó que se procura establecer si la bacteria -cuya presencia fue confirmada- resultó la causa final del deceso, aunque todo así lo indica.
En tanto, en la provincia de Catamarca un niño falleció la semana pasada, según se confirmó en el Boletín de Vigilancia Epidemiológica de la Secretaria de Salud de la Nación, pero no se informaron sus datos y el caso se conoció públicamente ahora.
Otro caso fatal informado en las últimas horas fue el de un joven de 15 años que falleció el último domingo en la ciudad de Cipolletti, en la provincia de Río Negro, según lo confirmó al portal LM la jefa del área de Epidemiología del hospital local, María Luz Riera, quien comentó que "el adolescente ingresó pesando 35 kilos, con una falla multiorgánica".
Además, la especialista comentó que una vez que el joven murió se le realizaron los exámenes complementarios y se le detectó la bacteria. En el último Boletín de Vigilancia Epidemiológica (que abarca el período desde el 19 de agosto al 14 de septiembre), en el que no estaban contabilizados los casos del nene de 2 años que murió en Miami, el del adolescente de 15 de Cipolletti, ni el del hombre de 77 de Mar del Plata, figuraban 16 casos confirmados de enfermedad invasiva por Streptococcus pyogenes.
De esos 16 casos, siete se convirtieron en víctimas fatales y las muertes ocurrieron en el Hospital Pedro de Elizalde de la Ciudad de Buenos Aires (2); en Rosario (1); en Posadas (1); en Río Negro (1); en Pergamino (1) y en Catamarca (1), este último el caso que se conoció públicamente hoy. Sumando ahora las otras tres víctimas.
Según el Boletín, y siempre refiriéndose a las muertes ocurridas hasta antes de este fin de semana, sólo dos casos refirieron factores de riego previos (varicela y escaraltina) y tres de los pacientes presentaron co-infección con influenza A.
La bacteria steptococcus pyogenes habitualmente produce afecciones en la garganta como anginas y faringitis, y en raras ocasiones se presenta en una forma agresiva que puede llegar a desembocar en casos fatales como los conocidos hasta ahora.
19-09-18. Fuente y Foto. Diariopanorama.comNACIONALES